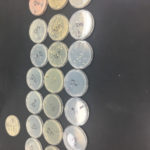
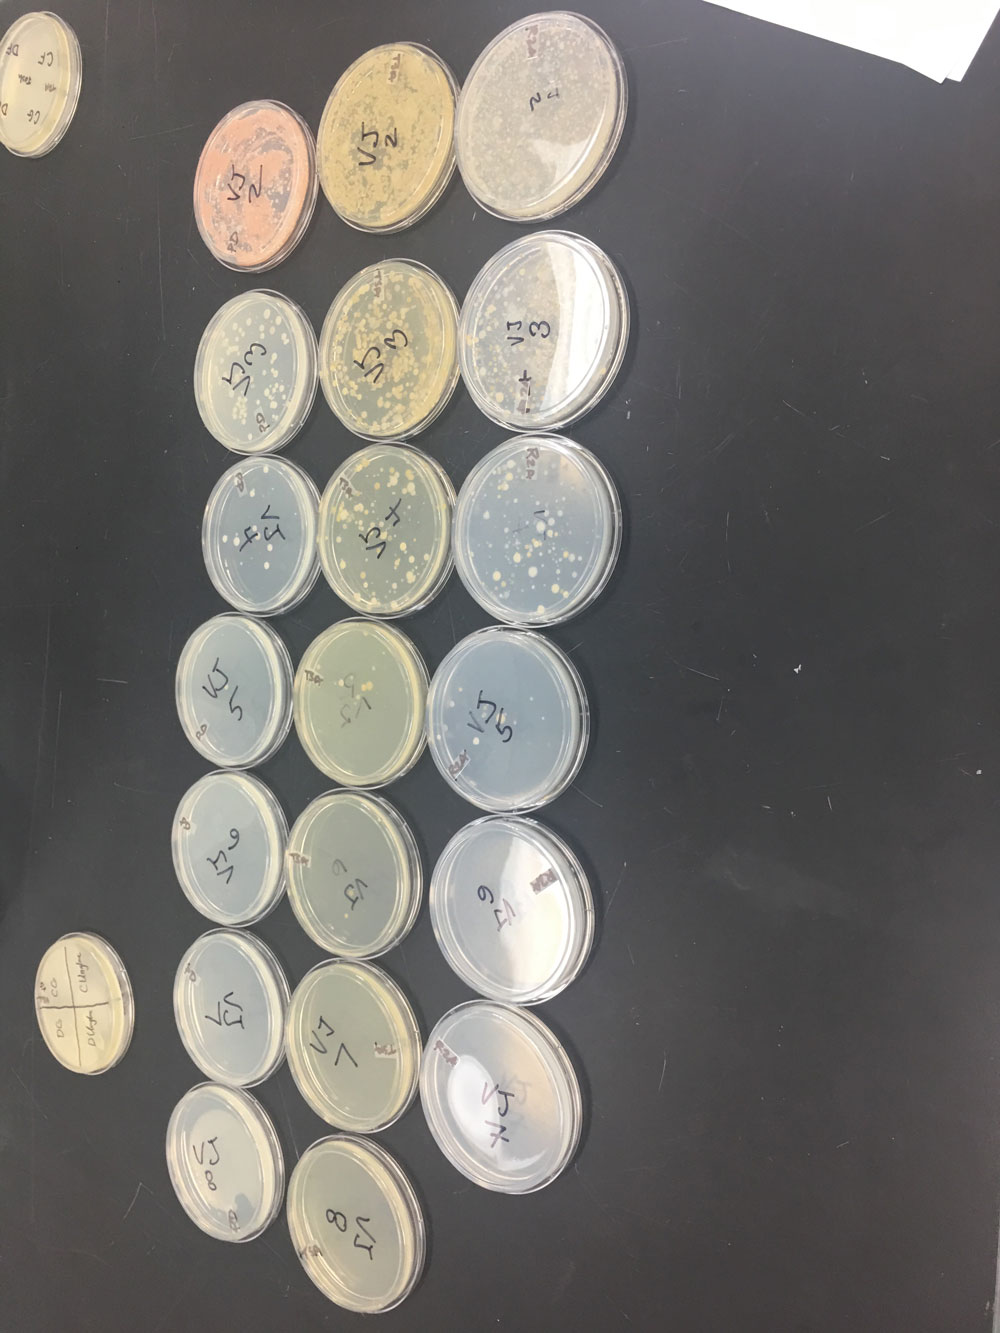

Official Selections

Space Biocontamination
Humans are on the verge of spreading to other planets, but will we spread our diseases and maybe bring some back to Earth?
Wed
1:00 pm
Sep 18
Tickets
Runtime:
The risks of contaminating other planets is a lesson we have learned exploring while spreading our diseases along the way. Another risk, not zero, is the risk of bringing life back to Earth. The U.S. and the rest of the spacefaring world has agreed to protect against both, but how well are we doing this? As we prepare for travel to planets that might support life, like Mars, should we do more to prepare for the worst?
Photos

Videos

Trailer